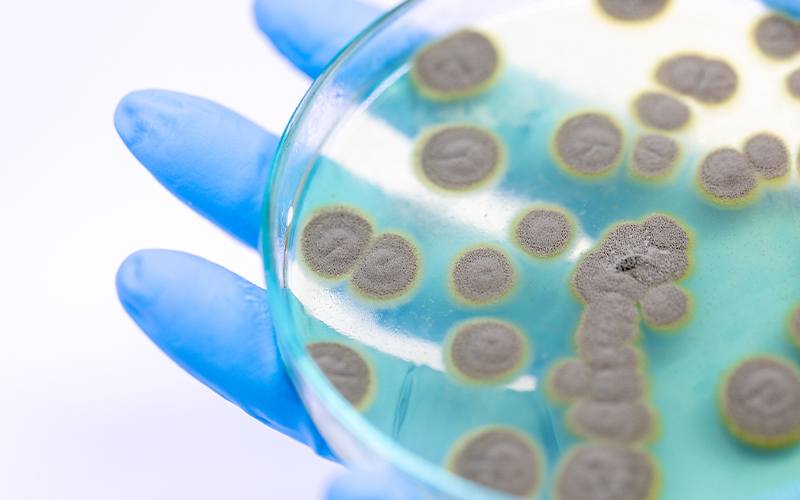
Laboratory mold culture Laboratory mold culture

The Labant Mould Incubator is engineered with precise temperature and humidity control and a uniform air circulation system, providing repeatable and verifiable cultivation conditions for moulds, biological samples, and microbial studies.

Whether in a research laboratory conducting microbiological experiments or in industries such as food, pharmaceuticals, and cosmetics, Labant delivers stable, safe, and efficient experimental support.
Wide Application Across Research and Industrial Fields
Food Industry: Safeguarding Food Safety and Shelf Life
In food testing and storage studies, the Labant Mould Incubator enables precise adjustment of temperature and humidity parameters to simulate various storage conditions, including high-humidity, ambient, or low-temperature environments.
It helps researchers assess mould contamination risks and preservative effectiveness, making it an ideal device for shelf life evaluation, mould growth testing, and packaging validation—providing quantifiable data for food safety and quality optimization.
Pharmaceutical Industry: Ensuring Drug Development and Stability Validation
In pharmaceutical research and production quality control, the Labant incubator supports the cultivation of moulds sensitive to specific drug compounds for efficacy testing and microbial challenge experiments.
Its highly accurate temperature control system can simulate extreme storage and transportation environments, enabling stability testing and antifungal verification—helping pharmaceutical manufacturers establish a comprehensive quality assurance framework.
Cosmetic Industry: Evaluating Preservative Systems and Product Safety

Since cosmetic products are susceptible to fungal contamination, the Labant Mould Incubator can reproduce realistic usage conditions such as high-temperature and high-humidity environments.
It allows researchers to observe fungal growth in different formulations and evaluate the effectiveness of preservative systems, helping brands identify potential risks in advance and ensure long-term product stability and consumer safety.
Environmental and Ecological Research: Exploring the Role of Moulds in Ecosystems

In environmental science, this incubator is widely used to study mould adaptability in soil, water, and air samples, as well as their roles in pollutant degradation and ecosystem restoration.
Through precise environmental simulation, researchers can systematically analyze fungal metabolism and survival mechanisms, providing valuable data for pollution control and bioremediation studies.
Public Health and Disease Prevention: Supporting Pathogen Detection
The Labant Mould Incubator is also applicable to public health and epidemiological research. It safely cultivates pathogenic fungi and microorganisms for sample testing, pathogen identification, and disease surveillance, supporting the establishment of robust epidemic prevention and control systems and providing reliable data for public health research.
Core Structural Design: Stable Operation with Intelligent Safety Protection
• Durable Cabinet and Sealed Chamber
The incubator features a high-strength cold-rolled steel exterior, combining durability with excellent thermal insulation.
The mirror-finish stainless steel interior is corrosion-resistant and easy to clean.
A double-layer tempered glass door allows real-time observation of samples while minimizing external temperature interference, and a silicone rubber sealing ring ensures excellent airtightness and environmental stability inside the chamber.
• Uniform Air Circulation System
An internal air duct and dedicated fan create forced convection of hot and cold air, ensuring even temperature and humidity distribution throughout the chamber.
This design eliminates localized deviations and enhances experimental repeatability and sample consistency.
• Safety and Alarm System
Equipped with an independent over-temperature alarm and power-off protection, the incubator automatically cuts off the heating source in the event of abnormal temperature rise, ensuring both sample and equipment safety.

Key Control System: High-Precision Temperature Regulation and Smart Operation
Precision Temperature Control
The Labant Mould Incubator adopts a “three-independent control architecture”:
Main temperature control system
Over-temperature protection system
Ambient monitoring system
These systems operate independently, ensuring stable and accurate temperature management within a range of 0–60°C.
With minimal temperature fluctuation, high resolution, and excellent uniformity, the device meets the demanding standards of both research and industrial applications.
Flexible Model Selection
Labant offers multiple standard capacities — 80L, 160L, 250L, and 300L — to accommodate different laboratory and quality control needs.
Users can select the optimal model based on sample volume, experimental duration, and available workspace, achieving a balance between practicality and efficiency.
Efficient Coordination of Core Components
The system integrates refrigeration, heating, humidification, UV sterilization, and air circulation modules:
The heating and cooling systems work in synergy to respond rapidly to temperature changes;
The humidification unit and humidity sensor maintain stable internal moisture levels;
The UV lamp provides chamber sterilization before and after cultivation, effectively preventing cross-contamination.
Precision Control Empowering Science and Industry
From food safety testing to pharmaceutical research, from cosmetic preservative evaluation to environmental studies, the Labant Mould Incubator delivers precise environmental control, intelligent operation, and reliable system stability.
It stands as a trusted partner for laboratories and production facilities seeking consistent and accurate cultivation performance.
If you require detailed technical specifications or an industry-specific customized solution, please contact our professional technical team.
We will provide targeted support and tailor-made configuration recommendations based on your experimental needs.
Follow on WeChat
Copyright @ 2024 Shanghai Welso Technology Co.,Ltd.